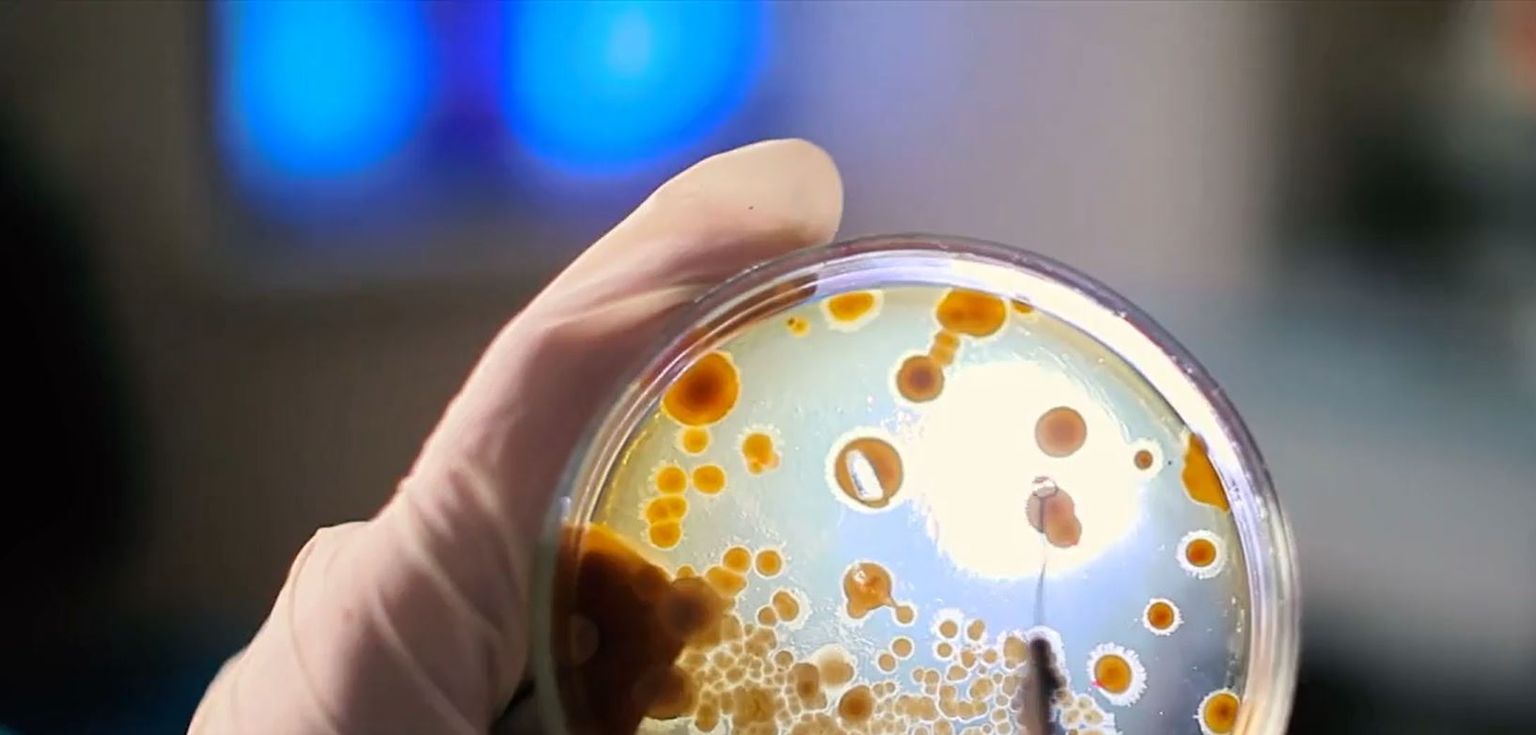

-
 Arjana Tambić Andrašević Foto: DNEVNIK.hr
Arjana Tambić Andrašević Foto: DNEVNIK.hr -
Otpornost na antibiotike - 1 Foto: DNEVNIK.hr
Otpornost na antibiotike - 1 Foto: DNEVNIK.hr -
 Otpornost na antibiotike - 2 Foto: DNEVNIK.hr
Otpornost na antibiotike - 2 Foto: DNEVNIK.hr -
 Otpornost na antibiotike - 3 Foto: DNEVNIK.hr
Otpornost na antibiotike - 3 Foto: DNEVNIK.hr -
 Otpornost na antibiotike - 4 Foto: DNEVNIK.hr
Otpornost na antibiotike - 4 Foto: DNEVNIK.hr -
Pogledaj i ovo





tragično ubojstvo mladića
Tko je zakazao? Sudac Vrhovnog suda: "Ne možete zatvoriti nekog samo zato što ga smatrate opasnim"





jedna osoba poginula
Naglo pale dionice MOL-a nakon snažne eksplozije u postrojenju, oglasio se Hernadi: "Ovo je operativna nesreća"





U DUBROVNIKU
Minirali uz more, susjedi se žalili da im oštećuju imovinu: Inspektorat donio odluku o spornom gradilištu

